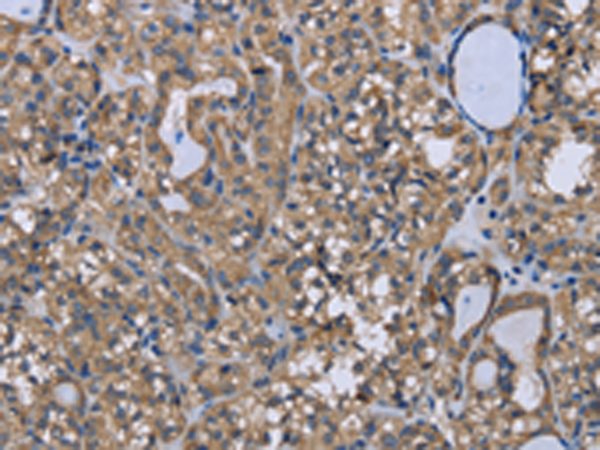

|
Background: |
This gene belongs to the forkhead family of transcription factors which are characterized by a distinct forkhead domain. The specific function of this gene has not yet been determined; however, it may play a role in myogenic growth and differentiation. Translocation of this gene with PAX3 has been associated with alveolar rhabdomyosarcoma. Interacts with LRPPRC. Interacts with RUNX2; the interaction inhibits RUNX2 transcriptional activity and mediates the IGF1/insulin-dependent BGLAP expression in osteoblasts Interacts with PPP2R1A; the interaction regulates the dephosphorylation of FOXO1 at Thr-24 and Ser-256 leading to its nuclear import. |
|
Applications: |
ELISA, IHC |
|
Name of antibody: |
FOXO1 |
|
Immunogen: |
Synthetic peptide of human FOXO1 |
|
Full name: |
forkhead box O1 |
|
Synonyms: |
FKH1, FKHR, FOXO1A |
|
SwissProt: |
Q12778 |
|
ELISA Recommended dilution: |
1000-2000 |
|
IHC positive control: |
Human thyroid cancer and Human liver cancer |
|
IHC Recommend dilution: |
25-100 |
購(gòu)物車
幫助
021-54845833/15800441009
